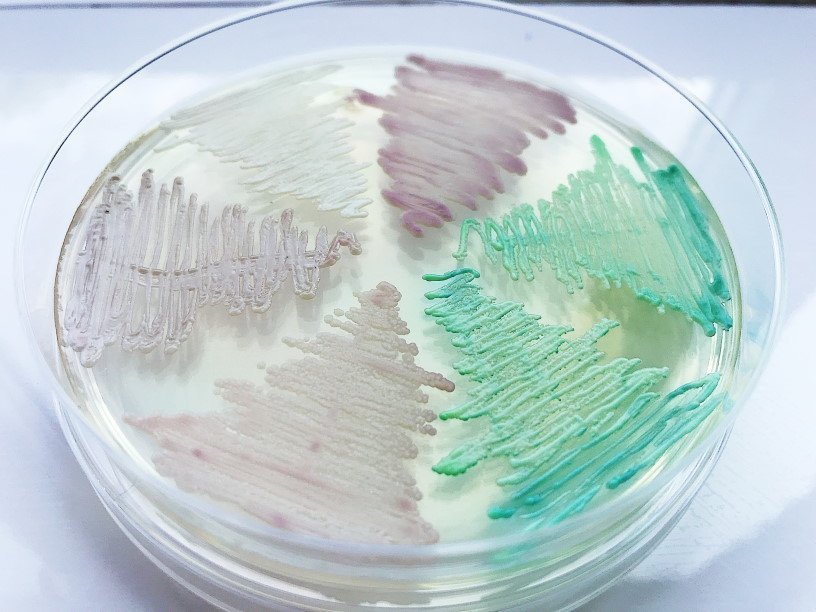

Екатерина Беленко: Промикробы: По грибы да по ягоды
Кандидоз, он же молочница, — это одна из разновидностей грибковой инфекции, вызывается она микроскопическими дрожжеподобными грибами. Угадайте, какого рода. Правильно, рода Candida. Представителей данного рода относят к условно-патогенным микроорганизмам. Это естественные обитатели различных частей организма человека, вызывающие заболевания при резком снижении общего или местного иммунитета. Микроорганизмы рода Кандида входят в состав нормальной микрофлоры рта, влагалища и толстой кишки большинства здоровых людей. Заболевание обусловлено не просто наличием этих малышей, а их размножением в большом количестве или попаданием более патогенных штаммов гриба. Наиболее часто встречаются (и красуются на фото) следующие виды — Candida albicans, Candida tropicalis, Candida glabrata, Candida krusei и Candida parapsilosis.
Человек очень рано знакомится с этими грибочками — их обнаруживают в околоплодной жидкости, плаценте и оболочках пуповины. Да и во время десанта во взрослый мир не избежать контакта, часто заселение кандидами происходит именно в момент прохождения родовых путей. Причины, по которым такие близкие соседи иногда выходят на тропу войны, — такие же, как у всех: сниженный иммунитет (а этому поводов масса — от трансплантации до ВИЧ), прием антибиотиков. Казалось бы, антибиотики — убийцы бактерий, а чтобы убить грибы, нужны антимикотики. Но прием мощных антибиотиков влияет и на активность кандид: устранили всех конкурентов, расчистили им плодородные лужайки — размножайся вовсю. Они такие шансы не упускают. Таким образом, необоснованное или неумелое использование антибиотиков широкого спектра способствует возникновению и стремительному развитию кандидоза.
Проявления кандидоза зависят от его локализации, существует деление на поверхностный и системный кандидоз. Поверхностные кандидозы включают в себя поражение кожи, ногтей, слизистых оболочек. Самый «известный» кандидоз — это, конечно, локализованный в половых органах. Не буду писать про зуд и выделения, невосприимчивые могут погуглить. Самая опасная форма этого заболевания — генерализованный кандидоз или даже грибковый сепсис. При таком тяжелом процессе поражаются многие внутренние органы, а кровь обеспечивает экспресс-доставку клеток гриба.
Генерализованная инфекция очень опасна для людей с постоянными мочевыми или внутривенными катетерами и для больных, принимающих продолжительный курс антибиотиков или постоянно делающих внутривенные инъекции.
Генерализованный кандидоз можно диагностировать по результатам посева культур из образцов крови, других биологических жидкостей или тканей. В поисках симптомов инфекционного поражения легких проводят флюорографию грудной клетки. Кроме того, для диагностики можно определить уровень специфических иммуноглобулинов, вырабатываемых организмом на антигены гриба Candida albicans. При отсутствии лечения инфекция распространяется по всему организму и может привести к смерти больного. Прогноз зависит от тяжести инфекции и общего состояния здоровья. Как говорится, берегите себя и своих близких.